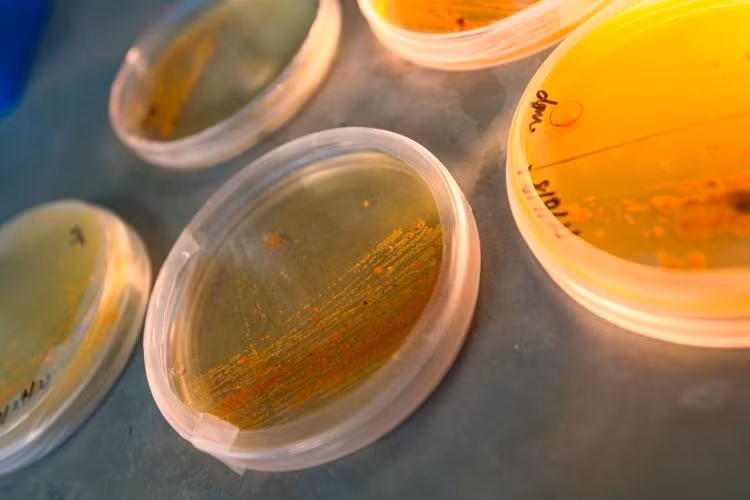

Phân tử chống ung thư salinosporamide A, được gọi là Marizomb đang trong giai đoạn thử nghiệm lâm sàng III để điều trị u nguyên bào thần kinh đệm, một loại ung thư não. Lần đầu tiên các nhà khoa học hiểu rõ được quá trình điều khiển bằng enzym kích hoạt phân tử.
Các nhà khoa học tại Viện Hải dương học Scripps thuộc Đại học California San Diego (UC San Diego) phát hiện được một loại enzyme có tên là SalC, tổ hợp phân tử chống ung thư, được gọi là “đầu đạn” chống ung thư salinosporamide. Quá trình này được giới thiệu chi tiết trong báo cáo khoa học, đăng trên tạp chí Nature Chemical Biology ngày 21/3.
Vi khuẩn Salinispora nuôi cấy trong Phòng thí nghiệm Moore tại Viện Hải dương học Scripps của UC San Diego. Ảnh: Erik Jepsen/UC San Diego
Salisporamide được nghiên cứu từ rất lâu tại Scripps và UC San Diego. Nhà vi sinh vật học Paul Jensen và nhà hóa học biển Bill Fenical của Scripps Oceanography phát hiện ra salinosporamide A và sinh vật biển tạo ra phân tử này khi thu thập vi khuẩn từ trầm tích vùng biển nhiệt đới Đại Tây Dương vào năm 1990. Một số thử nghiệm lâm sàng trong quá trình phát triển thuốc đã được thực hiện tại Trung tâm Ung thư Moores tại UC San Diego Health.
GS Bradley Moore, đồng tác giả nghiên cứu cho biết, phân tử salinosporamide có khả năng đặc biệt vượt qua hàng rào máu não, đây là nguyên nhân khiến phân tử có kết quả tốt trong những thử nghiệm lâm sàng đối với u nguyên bào thần kinh đệm. Phân tử có cấu trúc vòng nhỏ nhưng phức tạp, bắt đầu từ một phân tử tuyến tính gấp lại thành một hình tròn phức tạp hơn.
Enzyme tạo ra phân tử salinosporamide rất phổ biến trong sinh học, đó là một chất tham gia vào quá trình sản xuất axit béo ở người và kháng sinh như erythromycin ở vi khuẩn.
Enzyme SalC thực hiện một phản ứng rất khác so với một ketosynthase bình thường. Một ketosynthase bình thường là một loại enzyme, hỗ trợ phân tử tạo thành một chuỗi thẳng. Nhưng enzime SalC tạo ra salinosporamide bằng cách hình thành hai cấu trúc vòng phức tạp, có phản ứng.
Các nhà khoa học không thể tạo ra một loại enzyme duy nhất, hỗ trợ phân tử hình thành cả hai cấu trúc vòng trong phòng thí nghiệm. Có được hiểu biết này, các nhà khoa học có thể biến đổi enzyme cho đến thấy được các dạng cấu trúc phân tử, cho phép điều trị các loại bệnh tật.
Vi khuẩn biển, được gọi là Salinispora tropica , tạo ra salinosporamide để tránh bị ăn thịt bởi những kẻ săn mồi. Salinosporamide A có tính năng hoạt tính sinh học, gây độc tế bào in vitro, ức chế proteasome để tiêu diệt tế bào ung thư.
Sự hiểu biết về quy trình tạo ra salinosporamide cho phép các nhà khoa học đặt ý tưởng phát triển enzime, cho phép tạo ra salinosporamide ức chế immunoproteasome. Mỗt loại salinosporamide là một phương pháp điều trị có tính chọn lọc cao đối với các bệnh tự miễn dịch, những bệnh khiến hệ thống miễn dịch tấn công chính cơ thể con người mà theo chức năng phải được bảo vệ.

![[GALLERY] Điện mặt trời gây sốc, lần đầu vượt than đá tại Mỹ](https://cdn.khoahocdoisong.vn/images/1b2523e10b654dc437050e25c07994576dc2af451e174bac7f281956b44ccb537b212e94ed829e0f3b378e0723cfc361/na-3.png.avif)









![[GALLERY] Khám phá tính năng Google Maps ít người biết nhưng cực kỳ hữu ích](https://cdn.khoahocdoisong.vn/images/fc6b1457645b26575fcbba0a62d9d7d4812c0b780cc5a76192223f48640c70267b212e94ed829e0f3b378e0723cfc361/sa-3.png.avif)



![[GALLERY] Kho báu mới của AI, thế giới sắp có sàn dầu mỏ số](https://cdn.khoahocdoisong.vn/images/471905ebcc3f64c54b9c607fe9b135674ae82c537a3895f085080484a8909931621d3234a01b5f9e0047cf99f25c6b00/mo-3.png.avif)

![[GALLERY] Sốc tình báo phương Tây chi triệu USD mua dữ liệu cá nhân](https://cdn.khoahocdoisong.vn/images/471905ebcc3f64c54b9c607fe9b13567ad7853dc1925bd097708707fe60286e31f9492e9eeaf0a573186386b5a0ff8b5/my-3.png.avif)

![[GALLERY] Gen Z bất ngờ mê iPod, điện thoại nắp gập để cai mạng xã hội](https://cdn.khoahocdoisong.vn/images/471905ebcc3f64c54b9c607fe9b1356742e56b4c240b55a72394bb9c3812a1068bf1d2f9272e973d1b5e7feea8ceab37/z-2.png.avif)
![[GALLERY]Bí mật trong bóng World Cup 2026, cảm biến gửi dữ liệu 500 lần/giây](https://cdn.khoahocdoisong.vn/images/4def3d9bb8f1fa6a0b5e4380ced4e9c601eb72e89bb67a13e035a5f158fab327586e80584984eb6f5f283b21fae04167/bal-3.png.avif)
![[GALLERY] Bỏ 200 USD/tháng vẫn hết quota, Anthropic bị kiện tập thể](https://cdn.khoahocdoisong.vn/images/4def3d9bb8f1fa6a0b5e4380ced4e9c656840f7162d746936d11d7898be7320ee1508b7cf2b7ae5bff11a0830867044a/kien-2.png.avif)

